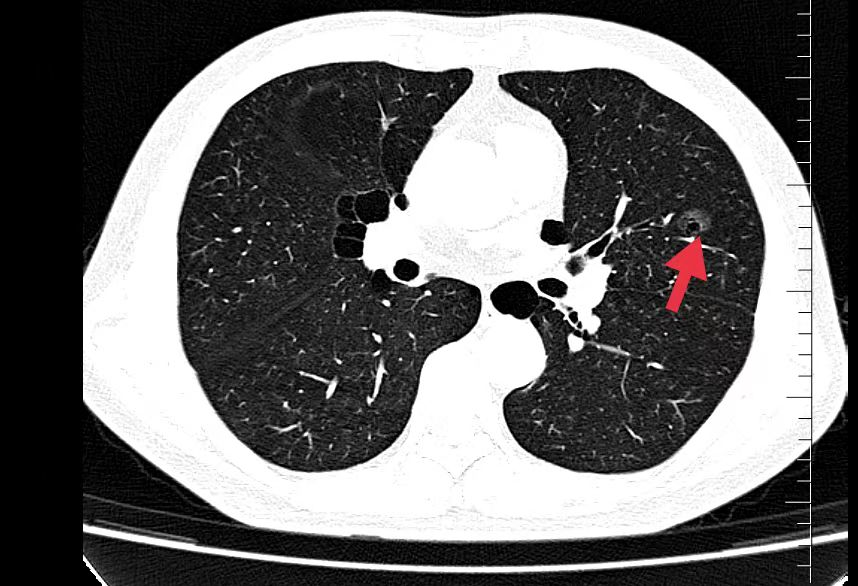

2023年8月仁泰集团全国九家体检部,发现重要异常检查结果631例,其中A类52例,包括高血糖、高血压、严重窦性心动过缓等,B类579例,其中包括恶性肿瘤(肺癌、甲状腺癌、肾癌、乳腺癌、膀胱癌、脑垂体瘤、肝胆管细胞癌等)、冠脉狭窄、肺部感染性疾病、甲状腺疾病、肾脏疾病、肝脏疾病、妇科疾病等。重要异常结果检出率为1.6%,回访率100%。这充分说明,健康体检对于早期发现健康隐患及重大疾病,并及时进行干预和处置,有着十分重要的意义。
重要异常检查结果占比排名前五的体检科室:
影像科占34%、彩超室占32%、检验科占21%、妇科占8.6%、心电图占3.5%。

重要异常检查结果排名前五的疾病类别分别为:
肺部疾病、甲状腺疾病、肝脏疾病、妇科疾病、肾脏疾病。

重要异常检查结果案例
01、**男士,55岁
于2023年8月18日在邯郸仁泰东区体检,冠脉CTA检查提示:冠脉前降支近段多发钙化及混合斑块,局部管腔狭窄多为55%左右,局部最窄处约达70%左右。左旋支中段钙化斑块,局部管腔狭窄约达90%左右。右冠状动脉近、中、远段多发钙化斑块,局部管腔狭窄约在26%-46%之间。建议客户到三甲医院进一步检查及诊疗。2023年8月25日跟踪回访,客户已在邯郸市第一医院进一步检查,与我院检查结果相同,等待床位支架治疗。

02、**男士,60岁
于2023年7月24日在邯郸仁泰东区体检,低剂量薄层CT扫描提示:左肺舌叶磨玻璃结节,大小约17mm。2023年7月25日首次回访,通知客户到三甲医院进一步检查和治疗。2023年8月30日跟踪回访,客户告知到邯郸市中心医院进一步检查,建议手术治疗,客户到北京肿瘤医院再一次检查同样建议手术治疗,已在北京肿瘤医院住院准备手术治疗。
03、**女士,62岁
于2023年8月12日在邯郸仁泰东区体检,甲状腺彩超检查提示:甲状腺大小正常范围,腺体内多发结节,较大位于右叶,大小约2.9*1.4cm中等回声结节,内回声不均匀,右叶另见低回声结节,大小约0.97*1.1cm,边界欠清,内见多发强回声团。2023年8月13日首次回访,通知客户到专科医院进一步检查和治疗。2023年8月30日跟踪回访,客户告知接到电话后分别去河北工大附属医院和邯钢医院检查,结果与我院检查结果一致,已选择在邯钢医院手术治疗,目前正在恢复中。

04、**男士,29岁
于2023年8月15日在宜昌仁康体检部体检,实验室及腹部彩超检查提示:AFP:130.11(已复查)ALT:155.1;AST:139.2;r-GT:621.5;彩超检查:肝内低回声1.9*1.5cm;肝实质回声不均。通知客户家属建议进一步检查。2023年9月5日跟踪回访,已在武汉某三甲医院进一步检查,确诊肝内胆管细胞癌,现治疗中。

05、**女士,54岁
于2023年8月16日在邯郸仁泰东区体检,膀胱彩超检查提示:膀胱内可见高回声团1.8*1.4cm,边界欠清、形态不规则,内回声不均匀,随体位改变移动不明显。CDFI:周边可见少量血流信号。2023年8月17日首次回访,通知客户到三甲医院进一步检查。2023年8月30日跟踪回访,客户家属告知,在北大医院复查,结果与我院一致,已在北大医院完成手术治疗,现出院在家休养。

06、**男士,65岁
于2023年8月15日在邯郸仁泰北区体检,膀胱彩超检查提示:膀胱充盈尚可,壁不厚,右侧壁见大小约0.6cm*0.4cm稍高回声,边界欠清,形态尚规整,内回声欠均匀,CDFI:未见明显血流信号。尿常规及镜检提示:尿潜血3+,镜检红细胞满视野。当日建议:客户进一步检查。2023年8月31日跟踪回访,客户家属告知,膀胱镜检查诊断为膀胱肿瘤,已住院准备手术。

07、**男士,58岁
于2023年8月18日在邯郸仁泰北区体检,脑核磁检查提示:左侧枕叶可见囊实性混杂信号,大小约1.8cmX1.3cm,周围可见片状水肿影。诊断: 左侧枕叶异常信号,建议客户到三甲医院进一步检查。2023年8月29日跟踪回访,客户告知,神经外科诊断脑肿瘤,已住院准备手术。

08、**女士,45岁
于2023年8月16日在邯郸仁泰西区体检,乳腺彩超检查提示:右侧乳腺约10点方向见大小约1.4*0.8cm低回声,边界欠清,形态欠规整,诊断:右侧乳腺低回声,建议客户进一步检查,明确病变性质。2023年8月31日跟踪回访,客户已在邯钢医院手术治疗,术后病理诊断乳腺癌。

09、**男士,55岁
于2023年8月6日在邢台仁泰体检部体检,腹部彩超检查提示:右肾实质部可探及大小约3.0*2.7cm低回声包块,CDFI:周边可见少许血流信号。考虑:右肾内占位性病变。建议客户到三甲医院进一步检查,明确病变性质。2023年8月12日跟踪回访,客户已在河北医科大学第二医院手术治疗。

10、**男士,62岁
于2023年8月10日在银川仁泰体检部体检,脑核磁检查提示:矢状位显示蝶鞍增大,鞍上池内T2WI、FLAIR示18.5*23mm等高信号、T1WI示等信号影。双侧上颌窦、筛窦、蝶窦粘膜增厚,考虑脑垂体腺瘤。建议客户到综合医院专科进一步检查。2023年8月25日跟踪回访,客户已到北京协和医院复查,明确诊断脑垂体瘤,准备手术治疗。

体检异常结果是受检者在无症状、无体征的情况下发现的某系统或某器官出现的异常,提示某些疾病存在的可能,需要进一步的医疗诊断和治疗,其中最重要的就是重要异常检查结果,如果这些结果能够早发现、早诊断并采取及时、规范的处置,可有效提高重大疾病的诊疗效果,甚至挽救受检者的生命。
仁泰健康管理集团各体检部严格按照《健康体检重要异常结果管理专家共识》的要求,认真做好重要异常结果的告知、处理及跟踪工作,使广大客户在第一时间了解自己存在的重大异常状况,并及时进行进一步的确诊和治疗。重大疾病的早期发现和及时治疗,极大地提高了相关疾病的治疗效果,有效改善了预后。仁泰体检通过全面、细致、准确的健康体检以及严格的质量控制管理,为客户创造了弥足珍贵的健康价值和生命价值。仁泰体检将一如既往的做好重要异常结果管理工作,真正为您的健康保驾护航。